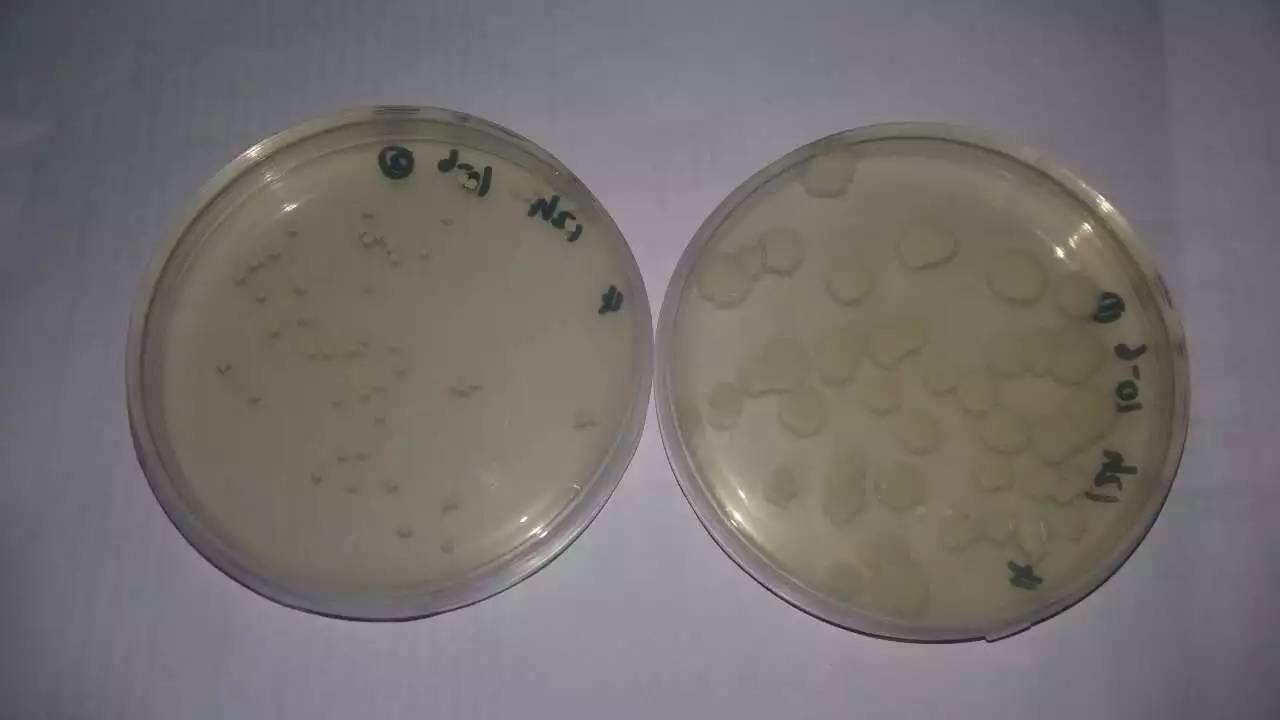

| 查看: 1042 | 回复: 12 | ||
Achilleswei金虫 (初入文坛)
|
[交流]
求解释
|
|
肖大爷1314
金虫 (小有名气)
- 应助: 17 (小学生)
- 金币: 1052.5
- 散金: 50
- 红花: 9
- 帖子: 209
- 在线: 54.5小时
- 虫号: 3616890
- 注册: 2014-12-28
- 专业: 微生物生理与生物化学

9楼2015-12-31 14:48:11
★
Achilleswei(金币+1): 谢谢参与
Achilleswei(金币+1): 谢谢参与
|
2楼2015-12-31 11:04:19
★
Achilleswei(金币+1): 谢谢参与
Achilleswei(金币+1): 谢谢参与
|
3楼2015-12-31 11:04:58
★
Achilleswei(金币+1): 谢谢参与
Achilleswei(金币+1): 谢谢参与
祝福 |
4楼2015-12-31 11:09:32
★
Achilleswei(金币+1): 谢谢参与
Achilleswei(金币+1): 谢谢参与
|
本帖内容被屏蔽 |
5楼2015-12-31 11:12:48
6楼2015-12-31 11:17:58
|
7楼2015-12-31 11:19:36
8楼2015-12-31 14:11:51
Achilleswei
金虫 (初入文坛)
- 应助: 0 (幼儿园)
- 金币: 805.9
- 散金: 10
- 帖子: 15
- 在线: 7.9小时
- 虫号: 2764435
- 注册: 2013-10-30
- 专业: 有机分子功能材料化学
10楼2015-12-31 15:41:42

回复此楼

